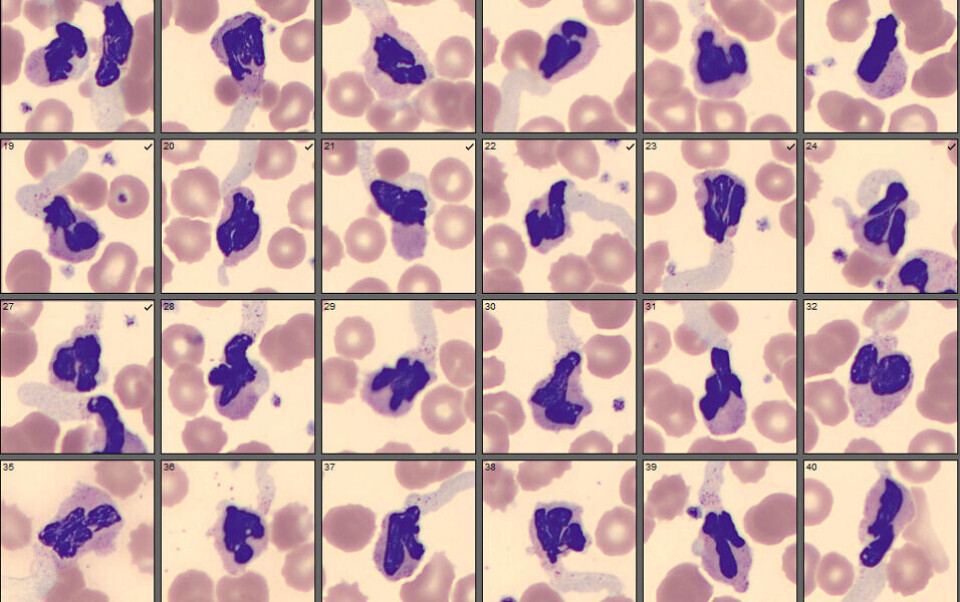

FAG resymé
Morfologisk unormale nøytrofile granulocytter ved covid-19
Fagbioingeniørene Inger Anne Tveit og Hege Zaar Nielsen ved Sykehuset i Arendal oppdaget tilfeldig at nøytrofile granulocytter hos noen covid-19-pasienter hadde unormal morfologi. Funnene er publisert i Tidsskrift for Den norske legeforening under sjangeren «Medisinen i bilder».
Bakgrunnen for artikkelen var at det i opplæringsøyemed ble laget blodutstryk fra en prøve som ikke var flagget med abnormal morfologi ved differensialtelling på analyseinstrumentet (Sysmex XN 9100).
Da utstryket ble mikroskopert (Cellavision), ble det oppdaget at de nøytrofile granulocyttene, til tross for manglende flagging, hadde svært annerledes morfologi enn normalt. Det mest påfallende ved morfologien var at alle cellene hadde en stor blå utposning fra cytoplasma, som i noen tilfeller inneholdt granula (figur 1).

I tillegg var mengden cytoplasma betydelig redusert og inneholdt ingen vakuoler og lite granula. Cellekjernens struktur var i liten grad endret i forhold til normal morfologi, med hensyn til segmentering, størrelse og fargeintensitet.
Funn hos tre av seks pasienter
Prøven som funnet ble gjort i, var tatt fem dager etter at pasienten ble innlagt. Dette førte til at flere pasientprøver fra innlagte covid-19 pasienter ble undersøkt. I tillegg til den første ble ytterligere fem pasienter fulgt opp med blodutstryk over tid, og samme fenomen ble funnet hos to andre pasienter. Den morfologiske endringen ble observert hos alle tre pasienter cirka tre-fire uker etter sykdomsdebut, og få dager senere var cellebildet normalisert. Pasientene hadde ulik alvorlighetsgrad av sykdommen, og to av dem fikk respiratorbehandling. Alle pasientene hadde i tillegg nøytrofili og lymfopeni, lymfocyttene hadde normalt utseende og var ikke aktiverte. En mulig forklaring på hvorfor cellebildet hos pasientene var normalisert etter få dager, er at granulocyttene har kort halveringstid - og at dette fenomenet antakelig foregår i en begrenset tidsperiode under infeksjonen.
Sammenheng med NETose?
Etter det forfatterne vet er det ikke publisert liknende funn knyttet til covid-19 pasienter. Men det vises til en studie hvor det ved hjelp av lungehistologi er påvist nøytrofile granulocytter som er innfiltrert i lungekapillærene hos covid-19 pasienter, og som muligens kan kobles til prosessen NETose. Dette er en prosess hvor nøytrofile granulocytter danner ekstracellulære feller (neutrophil extracellular traps, NET), et nettverk av tråder med kjerneholdig protein og protein for å omslutte patogener for destruksjon. Det spekuleres i om det påfallende cellebildet kan ha sammenheng med pågående NETose.
Artikkelen og arbeidet til bioingeniørene viser hvor spennende utfallet kan bli når man oppdager noe man stusser over i laboratoriehverdagen og utforsker det nærmere. Det blir interessant å følge med på om andre gjør liknende funn, og om dette kan bidra til økt kunnskap om immunresponsen mot SARS-CoV-2.
Referanse
- Tveit IA, Nielsen HZ. Morfologisk unormale nøytrofile granulocytter ved covid-19. Tidsskr Nor Legeforen. 2020; Epub 1.7.2020.